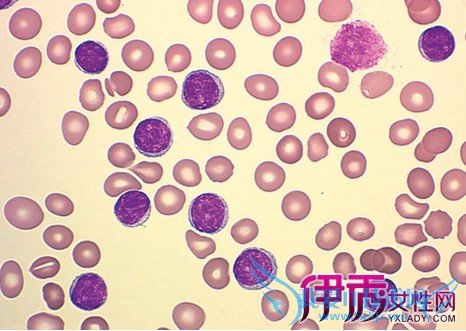

白细胞数值偏低会不会引起背痛? 注意事项早知道【图】
白细胞 偏低会不会引起背痛
白细胞旧称白血球,是血液中的一类细胞,通常被成为免疫细胞。血液中的白细胞是人体防御细菌入侵的巡逻兵,有人体“白色卫士”之称。白细胞数减少,就会削弱人体抗菌能力。
白细胞旧称白血球。血液中的一类细胞。白细胞也通常被成为免疫细胞。血液中的白细胞是人体防御细菌入侵的巡逻兵。当细菌等异物入侵时,白细胞便进入被入侵部位,将细菌包围、吞噬、消灭,故白细胞有人体“白色卫士”之称。可见白细胞数减少,就会削弱人体抗菌能力,容易受感染。不过,白细胞减少并不一定要治疗,一要看减少程度;二要看减少原因。正常白细胞数为(4~10)×109/升,通俗说就是每立方毫米4000~10000个,平均值则为7000个。如果介于4000~7000表示正常偏低,不需治疗;如果低于4000个,就可诊断为白细胞减少症。即使如此,也不一定就需要治疗,比如说,仅仅是轻度减少或一过性减少,复查时未继续下降,又毫无症状或不适,那就不必紧张,也无需治疗。当然,下列情况下的白细胞需要关注,并在医生指导下,采取干预措施。
白细胞 偏低会不会引起背痛
白细胞旧称白血球,是血液中的一类细胞,通常被成为免疫细胞。血液中的白细胞是人体防御细菌入侵的巡逻兵,有人体“白色卫士”之称。白细胞数减少,就会削弱人体抗菌能力。

白细胞偏低一般不会引起腰背部疼痛,主要影响机体抵抗力。白细胞减少常见于服用镇痛药、磺胺类药物,病毒感染,免疫系统衰弱,放化疗的影响。腰背部疼痛可能由于长期体力劳动引起,建议及时查个要不X片,同时局部可以按摩,促进粗布血液循环。白细胞如果不是很低,没有实际临床意义,可以不用服用升白细胞药物,如果较低,建议直接静脉注射用药,同时查个血常规,看看血红蛋白,血小板情况,是否有骨髓异常病变。
白细胞 偏低会不会引起背痛
白细胞旧称白血球,是血液中的一类细胞,通常被成为免疫细胞。血液中的白细胞是人体防御细菌入侵的巡逻兵,有人体“白色卫士”之称。白细胞数减少,就会削弱人体抗菌能力。

- 评论列表(网友评论仅供网友表达个人看法,并不表明本站同意其观点或证实其描述)
-
